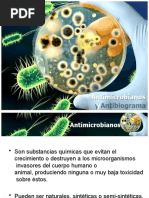

0% encontró este documento útil (0 votos)
31 vistas7 páginasGuía de Antibióticos y Su Uso
Este documento proporciona información sobre conceptos básicos de farmacología antiinfecciosa, incluyendo definiciones de antibióticos, bactericidas, bacteriostáticos, cepas sensibles y resistentes. Explica la prueba de sensibilidad antibiótica y su interpretación, y clasifica los antimicrobianos según su mecanismo de acción y su uso para tratar diferentes tipos de infecciones.
Cargado por
fgmendez-esDerechos de autor
© © All Rights Reserved
Nos tomamos en serio los derechos de los contenidos. Si sospechas que se trata de tu contenido, reclámalo aquí.
Formatos disponibles
Descarga como DOCX, PDF, TXT o lee en línea desde Scribd
0% encontró este documento útil (0 votos)
31 vistas7 páginasGuía de Antibióticos y Su Uso
Este documento proporciona información sobre conceptos básicos de farmacología antiinfecciosa, incluyendo definiciones de antibióticos, bactericidas, bacteriostáticos, cepas sensibles y resistentes. Explica la prueba de sensibilidad antibiótica y su interpretación, y clasifica los antimicrobianos según su mecanismo de acción y su uso para tratar diferentes tipos de infecciones.
Cargado por
fgmendez-esDerechos de autor
© © All Rights Reserved
Nos tomamos en serio los derechos de los contenidos. Si sospechas que se trata de tu contenido, reclámalo aquí.
Formatos disponibles
Descarga como DOCX, PDF, TXT o lee en línea desde Scribd